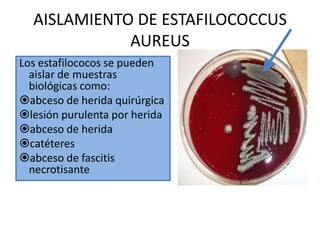
lesión purulenta por herida

Este documento trata sobre las infecciones intrahospitalarias (IIH). Define las IIH y explica su origen a través de la cadena de transmisión de agentes patógenos. Detalla los principales microorganismos responsables como Escherichia coli, Klebsiella pneumoniae y Staphylococcus aureus. Explica la clasificación, prevalencia y costos de las IIH en diferentes países. Finalmente, cubre conceptos y métodos clave para la prevención y control de IIH como lavado de manos, uso de barreras, condiciones quirúrgicas